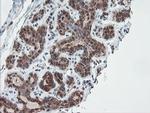
SENP2 Antibody in Immunohistochemistry (Paraffin) (IHC (P))

Search
OriGene
SENP2 Monoclonal Antibody (OTI3E7), TrueMAB™
{{$productOrderCtrl.translations['antibody.pdp.commerceCard.promotion.promotions']}}
{{$productOrderCtrl.translations['antibody.pdp.commerceCard.promotion.viewpromo']}}
{{$productOrderCtrl.translations['antibody.pdp.commerceCard.promotion.promocode']}}: {{promo.promoCode}} {{promo.promoTitle}} {{promo.promoDescription}}. {{$productOrderCtrl.translations['antibody.pdp.commerceCard.promotion.learnmore']}}
产品信息
CF800127
种属反应
宿主/亚型
分类
类型
克隆号
抗原
偶联物
形式
浓度
规格
纯化类型
保存液
内含物
保存条件
运输条件
产品详细信息
For reconstitution, we recommend adding 100 µL distilled water to a final antibody concentration of about 1 mg/mL. To use this carrier-free antibody for conjugation experiments, we strongly recommend performing another round of desalting. (Zeba Spin Desalting Columns, 7KMWCO, 0.5 mL, Product # 89882)
靶标信息
SUMO is a small ubiquitin-like protein that can be covalently conjugated to other proteins. SENP2 is one of a group of enzymes that process newly synthesized SUMO1, SUMO2, and SUMO3 into the conjugatable mature forms and catalyze the deconjugation of these same SUMO proteins from their targeted substrates. SENP2 may also down-regulate CTNNB1 levels and thereby modulate the Wnt pathway.
仅用于科研。不用于诊断过程。未经明确授权不得转售。
篇参考文献 (0)
生物信息学
蛋白别名: Axam2; CT; sentrin (SUMO1) specific peptidase 2; Sentrin-specific protease 2; Sentrin/SUMO-specific protease SENP2; SMT3-specific isopeptidase 2; Smt3ip2; SUMO1/sentrin/SMT3 specific peptidase 2; SUMO1/sentrin/SMT3 specific protease 2; unnamed protein product
基因别名: AXAM2; KIAA1331; SENP2; SMT3IP2
UniProt ID: (Human) Q9HC62
Entrez Gene ID: (Human) 59343